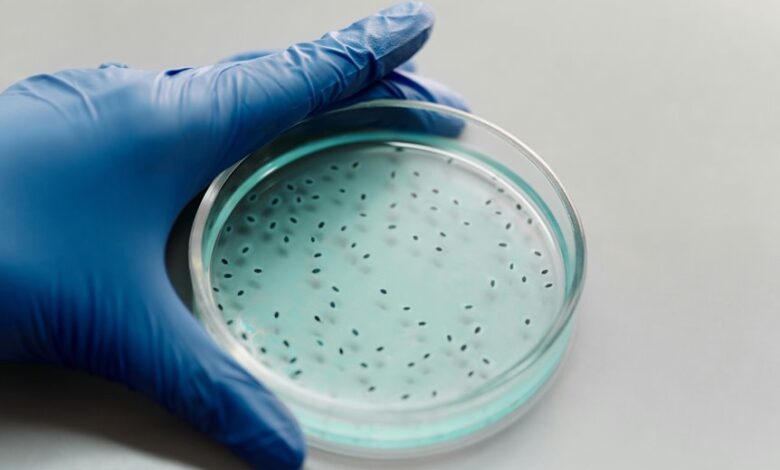
scientific keyword discovery hub context

Scientific Keyword Discovery Hub Raphaelepsis Explaining Biological Research Queries
Raphaelepsis translates biological questions into standardized terms that map to core concepts, entities, and processes. It guides keyword discovery through an iterative workflow, aligning vocabulary with ontologies while preserving intellectual autonomy. The approach supports reproducible searches across literature, datasets, and tools, offering evidence-driven criteria to balance precision and recall. This framework leaves room for refinement as new data emerge, inviting further exploration of how structured queries shape discovery pathways and reproducible outcomes.
How Raphaelepsis Translates Biological Questions Into Keywords
Raphaelepsis translates biological questions into keywords by mapping the core aims, entities, and processes described in a query to standardized terms used across biomedical databases. Through translating questions, researchers illuminate intent; keyword mapping guides extraction. Iterative refinement of terms aligns with concept ontologies, ensuring consistent interpretation and interoperability, while preserving intellectual freedom to explore diverse hypotheses within rigorous, evidence-driven frameworks.
The Keyword Discovery Workflow for Biological Research
The Keyword Discovery Workflow for Biological Research delineates a systematic process to transform complex scientific questions into searchable, interoperable terms. It guides translate biology into structured concepts, enabling keyword mapping, data synthesis, and targeted literature search. Emphasizing workflow optimization and reproducibility checks, the approach remains concise, evidence-driven, and audience-aware, fostering intellectual freedom while maintaining rigorous, transparent methods.
Using Keywords to Locate Relevant Literature, Datasets, and Tools
How can precise keyword selection improve the retrieval of literature, datasets, and tools in biological research? It describes translating questions into actionable terms, building vocabularies that align with search strategies, and leveraging keyword scoring to guide query expansion. Throughout, researchers focus on discovering datasets, tools, and literature, optimizing search strategies while avoiding redundancy and embracing a liberated, evidence-driven approach.
Evaluating Keywords for Precision, Recall, and Reproducibility
Evaluating keywords for precision, recall, and reproducibility centers on measuring how effectively chosen terms retrieve relevant literature, datasets, and tools while limiting irrelevant results and enabling consistent replication.
The assessment emphasizes precision assessment as a metric and examines reproducibility challenges across databases, search interfaces, and study designs.
Clear, evidence-driven criteria support transparent taxonomies, improving discovery, comparability, and user autonomy in scholarly inquiry.
Conclusion
Raphaelepsis, a smug alphabet soup for scientists, proudly translates questions into ontological breadcrumbs, then pretends precision is a magic wand. It touts reproducibility while juggling vocabularies, workflows, and glossaries like a circus of terms. The satire implies that if queries are mapped, metrics will bow, and papers will cascade forth. In truth, the hub offers a disciplined, evidence-driven framework: clarify questions, align with ontologies, and iteratively refine keywords to improve search quality—without surrendering the messy charm of real science.